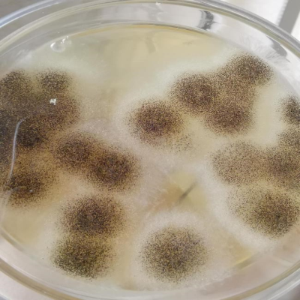
165354534956232047.png 3084330 (2).png

中国药典收载的微生物限度检查、无菌检查、方法适用性及培养基适用性试验,都需要用到菌株,黑曲霉作为5种标准菌株之一,大家都十分熟悉,然而对于巴西曲霉却是了解不多,许多药企会产生两者是否一样、能否通用的疑问。
目前,中国药典指定的黑曲霉是来源于CMCC(中国医学微生物菌种保藏管理中心),编号为CMCC(F) 98003,美国药典(USP)则要求是来源于ATCC(美国典型菌种保藏中心),编号为ATCC 16404的菌株。在2010年前,两者分类学的名称均为黑曲霉,但随着系统分类学和分子生物学的发展,表型分析结合基因型分析的多相鉴定技术的出现,ATCC 16404的分类学名称由黑曲霉更改为巴西曲霉。
黑曲霉(A. niger)和巴西曲霉A. brasiliensis)同为曲霉属的丝孢类真菌,在形态学上很难区分,只有在电子显微镜下才能看出孢子的差异性。黑曲霉最早由S.M. Ringel从蓝莓中分离得到,于1970年开始美国药典(USP 18)中正式采用ATCC 16404作为丝孢类真菌的代表菌种用于防腐效能验证试验,随后世界各国标准开始广泛采用ATCC 16404作为标准菌株。而巴西曲霉是在2007 年由Ja’nos Varga 等人通过研究在世界范围内分离出来的31株黑曲霉中发现的一个新种。到了2008 年,ATCC 研究人员Jan Houseknecht等人通过多相鉴定技术对ATCC 16404进行了复核鉴定,发现ATCC 16404与巴西曲霉模式菌株 IMI 381727T 的表型和基因型完全符合,而与黑曲霉模式菌株ATCC 16888的基因型则存在明显差异,确定是不同的两个种,证明ATCC 16404应该为巴西曲霉。由此,ATCC16404成为美国药典历史上第一株更名的标准菌株,于2010美国药典中正式更名为巴西曲霉,随后,世界微生物菌种数据中心(WDCM)也进行了同步更新。
由此可见,CMCC(F)98003与ATCC16404是不可以通用的,其它4种标准菌株虽然名称一致,但是按照中国药典的规定,我们制定标准或者进行试验采用的标准菌株都应该来源于CMCC。到目前为止,还没有相关研究对CMCC(F)98003黑曲霉进行复核鉴定,是否需要更名,还有标准菌株如何与国际保持统一,这些都是需要继续探讨的内容。

发表评论